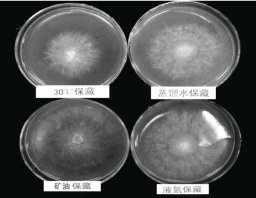

【作者】 丁湖广;
【机构】 福建省古田县新元Manbetx体育手机版推荐A9版本研究所;
【摘要】 <正>银耳培养料栽培是取代传统的木材(原木或段木)栽培,主要以杂木屑、棉籽壳等为原料,辅以麦麸、蔗糖、石膏等作为培养料,进行塑料袋或罐、瓶式栽培。目前我国银耳产量的95%为培养料袋栽。1银耳栽培季节 更多还原
ManBetX体育 银耳; 栽培季节; 培养料; 配方; 配制; 装袋; 灭菌;
【文内图片】

石膏粉撒于料面

测含水量料紧而合拢3圈,装料灶的吞料面打穴5·1定料袋有穴口贴封5·3胶为3·25物,随之紧贴
钢板单体灭菌仓6·1合2小时内而上重

连体灭菌柜不掺冷升温较

钢板锅灭菌灶更多图片...
【分类号】S567.34
